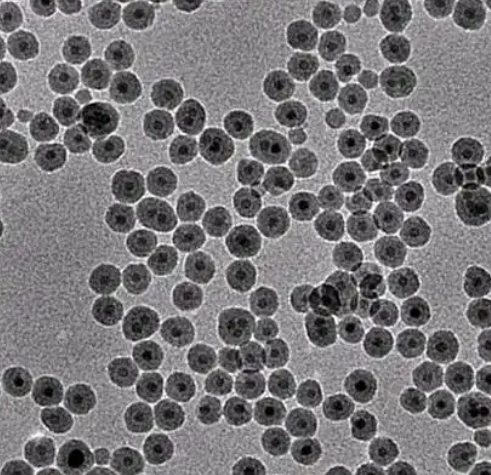
聚多巴胺纳米粒子（100 nm）

聚多巴胺纳米粒子(100 nm)
中文名称:聚多巴胺纳米颗粒(约100 nm)
英文名称:Polydopamine Nanoparticles (PDA NPs, 100 nm)
一、结构性质
聚多巴胺(PDA)为源于海洋贻贝粘附机制的人造高分子材料,通过多巴胺在弱碱性条件下自聚合形成球状纳米粒。其表面富含酚羟基、醌基、胺基等官能团,具有良好生物相容性、还原性、金属螯合和药物负载能力。
二、制备方法
在pH 8.5 Tris缓冲溶液中溶解多巴胺;
在室温下自氧化聚合形成PDA纳米粒子;
离心收集并多次洗涤;
可进一步修饰(如PEG化、负载药物、结合靶向配体)。
三、应用领域
药物递送:载药能力强,响应性释放(pH、还原等);
光热治疗:PDA具备良好光吸收能力(近红外区);
靶向修饰平台:易修饰多种功能基团,用于分子靶向、免疫检测;
组织修复/粘附材料:PDA在水凝胶、支架材料中提升细胞黏附与生长。
四、技术优势
天然来源,结构稳定;
多功能表面官能团,便于生物连接;
材料通用性强,适配多种载药/复合平台;
尺寸均一,生物分布良好。
无机纳米定制服务
关于我们:
西安齐岳生物提供的无机纳米定制服务专注于氧化物、金属、量子点、磁性材料等无机纳米颗粒的个性化设计与合成。可定制粒径(5\~500nm)、形貌(球形、棒状、花状、中空)、组成(如Fe₃O₄、TiO₂、ZnO、金纳米、量子点)及表面功能化(如羧基、氨基、PEG修饰)。广泛应用于药物递送、成像、催化、传感及肿瘤*疗等领域。可提供高分散性、批次稳定性强的科研级或产业级材料,附带TEM/SEM、DLS、Zeta电位、元素分析等表征数据,支持复配定制服务。
以上资料由小编zhn提供,仅用于科研
相关推荐:
油溶性NaYF4:5%Tm@NaYF4:25%Yb@NaYF4纳米粒子
少层氮化硼纳米片分散液
巯基修饰的氧化石墨烯纳米片
纳米硒(25-55nm)
羟基修饰氮化硼纳米片
小尺寸金纳米片
30nm纳米氧化锌CAS1314-13-2




齐岳微信公众号
官方微信
库存查询